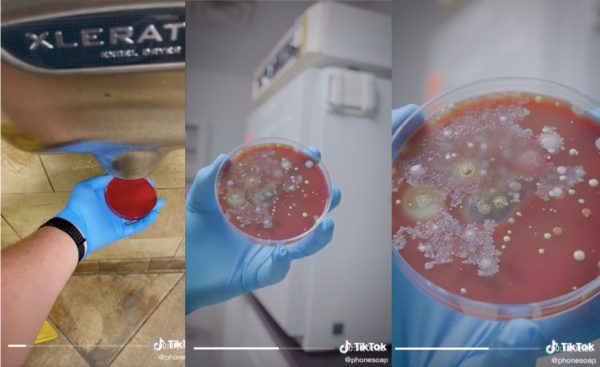
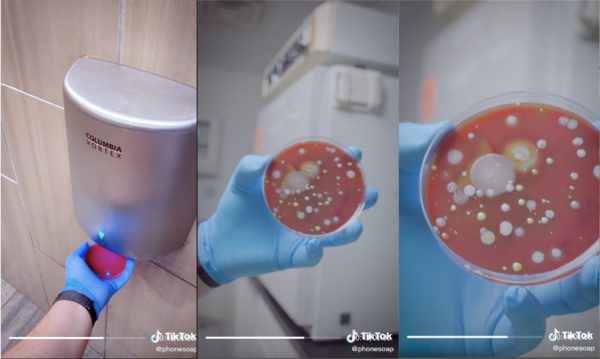

视频 | 用公厕烘手机后布满细菌 美公司实验:潜伏的细菌很惊人


(八打灵再也14日讯)在公共厕所洗手后,你会用纸巾擦干手部,还是使用烘手机烘干?
美国一家紫外线消毒器公司日前做了一项实验,他们分别到公共厕所、油站和电影院的厕所使用烘手机,实测使用后会有多少细菌附着在手上。
ADVERTISEMENT
根据他们在TikTok上传的实验视频,可见他们使用4个培养皿代替手部,第一个培养皿是模拟洗手后上下晃动让其自然干,另外三个培养皿则是使用厕所里的烘手机烘干,接着实验人员把培养皿放入培养箱等待三天。
三天后,实验人员取出培养皿对照后发现了令人意外的结果,自然干的培养皿上没有肉眼可见的细菌,另外三个用了烘手机的培养皿都培养出大量的细菌,相当恶心,也意味着烘干机“潜伏”的细菌数量惊人。

美国公司的这段实验视频在社交媒体疯传,短短2天便累计了650万观看次数;他们也指出,使用纸巾抹干是最好且卫生的做法。
有网民看了视频后表示,“我听到有人形容烘手机吹出来的风犹如‘上千个屁’,我已经不再使用烘手机了。”
也有网民表示,经历过疫情,现在一些公共厕所内会提供消毒液,方便民众洗手后消毒手部。
@phonesoap How germy are hand air dryers…again?#PrimeDayDreamDeals #phonesoap ♬ original sound – PhoneSoap
ADVERTISEMENT
热门新闻
百格视频
ADVERTISEMENT
